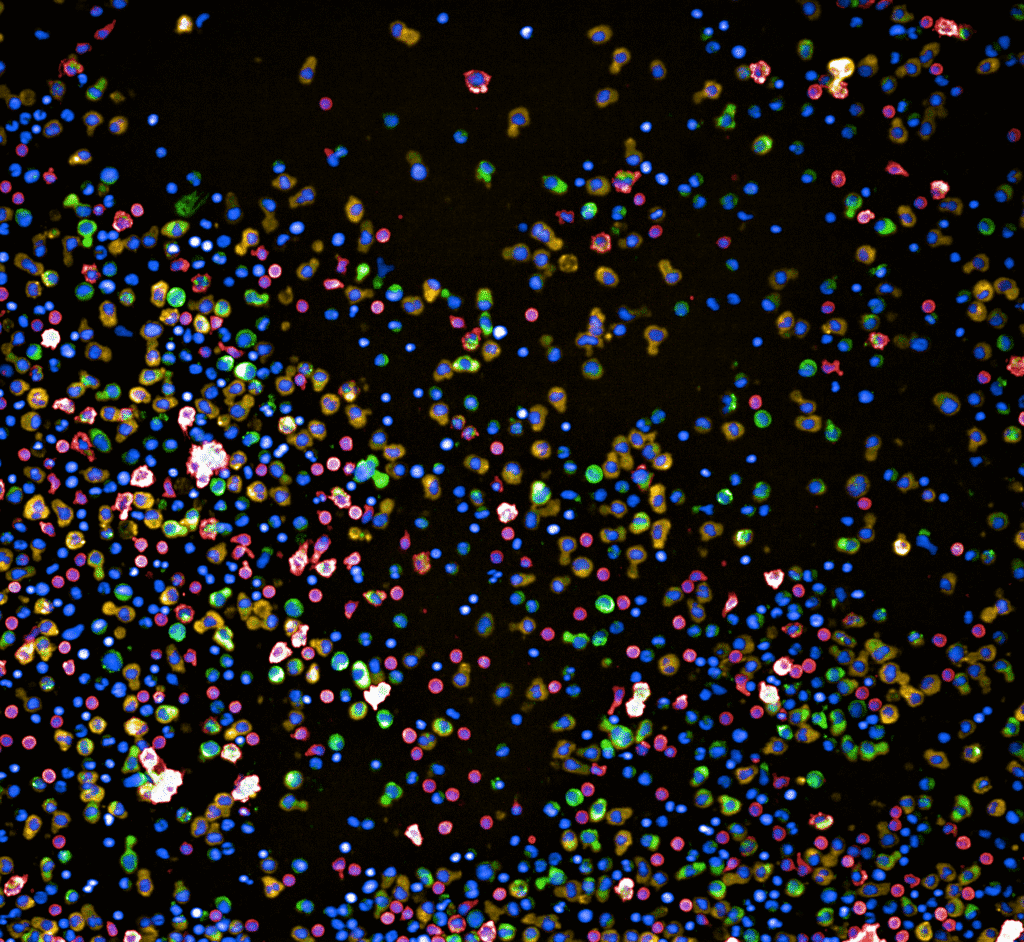
MM026 A9 01 Bh01 1024x942

4.09.2025
Fachbereich
Krebserkrankungen des Blutes und Lymphsystems – Neue Behandlungsansätze durch Forschung
Unser spezialisiertes Zentrum für Hämatologische Neoplasien bietet Patientinnen und Patienten mit bösartigen Erkrankungen des Blutes und lymphatischen Systems eine umfassende, individuell abgestimmte Behandlung. Durch interdisziplinäre Zusammenarbeit, modernste Diagnostik und den Einsatz neuester wissenschaftlicher Erkenntnisse gewährleisten wir eine Versorgung auf höchstem medizinischem Niveau.

Überblick
Hämatologische Neoplasien sind bösartige Erkrankungen des Blutes, des Knochenmarks oder des Lymphsystems. Dazu zählen unter anderem Leukämien, Lymphome und das Multiple Myelom. Im Gegensatz zu soliden Tumoren betreffen diese Erkrankungen oft den gesamten Körper, da sich die Krebszellen über das Blut- und Lymphsystem ausbreiten können.
September ist Blutkrebs-Monat
Jeden September wird weltweit auf Blutkrebs (Leukämie, Lymphome, Myelome) aufmerksam gemacht. Ziel ist es, das Bewusstsein für diese Erkrankungen zu stärken, Betroffene zu unterstützen, über Fortschritte in Forschung und Behandlung zu informieren. Forschung zu stärken ist entscheidend, um neue Therapien zu entwickeln und Heilungschancen zu verbessern.
Nutzen Sie diesen Monat, um sich, Familie und Bekannte zu informieren, Fragen zu stellen oder sich zur frühen Erkennung von Blutkrebs beraten zu lassen.
Mehr zu den einzelnen Krankheitsbildern erfahren.
Im Zentrum für Hämatologische Neoplasien ermöglichen modernste Analysetechniken in unseren Laboren eine präzise Diagnosestellung. Die Therapie richtet sich nach der genauen Erkrankungsform, dem individuellen Verlauf und dem allgemeinen Gesundheitszustand. Unser breites Behandlungsangebot umfasst zielgerichtete System- und Immuntherapien sowie autologe und allogene Blutstammzelltransplantationen und Immunzell-Therapien.
Unser Ziel ist es, die Erkrankungen zu heilen, Rückfälle zu verhindern und die Lebensqualität der Patientinnen und Patienten zu erhalten oder zu verbessern. An unserem Zentrum erfolgt die Behandlung im Rahmen einer engen interdisziplinären Zusammenarbeit und unter Einbezug neuester Forschungserkenntnisse. Dies ermöglicht es uns, die wirksamste und eine individuell abgestimmte Therapie anzubieten. Unser Behandlungsteam begleitet Patientinnen und Patienten von der Diagnose über die Therapie bis zur Nachsorge – stets mit Blick auf die persönlichen Bedürfnisse.
“Was unser Zentrum auszeichnet, ist die enge Verbindung von spezialisierter Diagnostik & Patientenversorgung, innovativer Forschung und fachübergreifender Zusammenarbeit – unter dem Dach des CCCZ als universitäres Exzellenzzentrum für Präzisionsonkologie. Diese Kombination gibt uns in der Schweiz ein Herausstellungsmerkmal.”
Prof. Markus G. Manz - Leiter Zentrum für Hämatologische Neoplasien am CCCZ

Interdisziplinäre Zusammenarbeit
- Enge Zusammenarbeit mit allen beteiligten Kliniken und Fachdisziplinen am USZ.
- Interdisziplinäre Fallbesprechungen in wöchentlichen Tumorboards zur individualisierten Therapieplanung.
- Vernetzung mit Zuweisenden durch strukturierte Kommunikation und gemeinsame Fallbesprechungen.
- Kontinuierliche Qualitätsverbesserung durch regelmässige nationale und internationale Zertifizierungen und Akkreditierungen.

Präzise Diagnostik
- Fundierte Erstabklärung und Diagnose von hämatologischen Neoplasien durch moderne labordiagnostische Verfahren inkl. Morphologie, Durchflusszytometrie und Zytogenetik.
- Molekulare Diagnostik als Basis für eine individuell angepasste Therapie im Sinne der Präzisionsmedizin.

Therapieangebote
- Anwendung aller evidenzbasierten Therapiekonzepte Chemotherapie, zielgerichteter Therapien und Immuntherapien. Pro Jahr werden >85 autologe und >80 allogene Blutstammzell-transplantationen sowie 30 CAR T-Zelltherapien an unserem Zentrum durchgeführt.
- Zugang zu neuen Medikamenten und Therapieansätzen durch Teilnahme an klinischen Studien (Phase I–IV). Klinische Studie finden

Ganzheitliche Begleitung
- Kontinuierliche Nachsorge, Psychoonkologie, Sozialberatung, Physio- und Ernährungstherapie als fester Bestandteil der Patientenbetreuung. Unsere unterstützenden Pflege-, Beratungs- und Behandlungsangebote
- Patientenveranstaltungen und Unterstützung bei der Vernetzung mit anderen Betroffenen und Selbsthilfegruppen. Mehr erfahren zu Patientenveranstaltungen und Patient Engagement am CCCZ
Einladung Patientenakademie Akute Myeloische Leukämie und Myelodysplastische Neoplasien:
Unsere Expertinnen und Experten informieren über aktuelle Entwicklungen in der Behandlung und Forschung zur Akuten Myeloischen Leukämie (AML) und Myelodysplastischen Neoplasien. Beim anschliessenden Apéro besteht die Möglichkeit zum persönlichen Austausch mit Fachpersonen und Betroffenen.
Ort: Universität Zürich, Kleine Aula, Gebäude RAA, Rämistrasse 59, 8001 Zürich
Datum: Montag, 18. September 2025, 18:30-19:45h
Wir freuen uns auf Ihre Teilnahme und den persönlichen Austausch.
Neue Behandlungsansätze durch Forschung
Ein zentraler Bestandteil unseres Zentrums ist die enge Verbindung von Forschung und Patientenversorgung. Unsere Forschungsschwerpunkte sind die molekulare Präzisionsonkologie, Immuntherapien und zelluläre Therapien. Dieser forschungsnahe, innovativer Ansatz hilft uns, Krebs gezielter, wirksamer und schonender zu behandeln.
In Zusammenarbeit mit führenden Forschungseinrichtungen – in Zürich, in der Schweiz und international – entwickeln wir neue Therapiekonzepte und bringen neueste wissenschaftliche Erkenntnisse direkt in die klinische Praxis. Davon profitieren Patientinnen und Patienten ganz konkret – durch Zugang zu modernsten, personalisierten Behandlungsverfahren und innovativen Therapieoptionen.
Beispiel 1 – ZURICAR
Unser Zentrum leitet des Projekt ZURICAR – einem wichtigen Leuchtturmprojekt, das durch das Comprehensive Cancer Center Zürich (CCCZ) finanziell gefördert wird. Ziel dieses Projekts (Leiterin: Prof. Dr. Chiara Magnani, MOH, USZ) ist es, neuartige Verfahren zu entwickeln, mit denen sogenannte CAR-Immunzellen schneller, sicherer und kostengünstiger hergestellt werden können.
Was bedeutet das für Patientinnen und Patienten?
CAR-Immunzellen sind eine spezielle Form der zellulären Immuntherapie. Dabei werden bestimmte Abwehrzellen (T-Zellen) aus dem Blut entnommen, im Labor gentechnisch so verändert, dass sie Krebszellen gezielt erkennen und angreifen können. Anschließend werden diese „trainierten“ Zellen wieder in den Körper zurückgegeben, wo sie die Krebszellen bekämpfen. Mehr lesen
Diese Therapie soll insbesondere Patientinnen und Patienten mit therapieresistenten Blut- oder Lymphkrebserkrankungen – also solchen, bei denen andere Behandlungen nicht ausreichend wirken – eine neue, vielversprechende Option bieten.
Mit dem ZURICAR-Projekt möchten wir sicherstellen, dass diese innovative Therapie in Zukunft schneller verfügbar, individuell anpassbar und für mehr Menschen zugänglich wird. Die enge Zusammenarbeit von Forschung, Klinik und Technik in Zürich macht es möglich, moderne Wissenschaft direkt zum Wohle unserer Patientinnen und Patienten einzusetzen.
Beispiel 2 – RAPID
Die RAPID-Studie (Pharmacoscopy-guided Clinical Standard-of-care in r/r AML) setzt sich zum Ziel, die Behandlungsmöglichkeiten für Patientinnen und Patienten mit rezidivierter oder refraktärer akuter myeloischer Leukämie (r/r AML) entscheidend zu verbessern.
Die randomisierte, kontrollierte klinische Studie (Studienleiter: Prof. Dr. Alexandre Theocharides, MOH, USZ) untersucht, inwiefern die sogenannte Pharmakoskopie – eine am Labor von Prof. Berend Snijder (ETH Zürich) entwickelte, funktionelle Plattform für Präzisionsmedizin – zur Auswahl der individuell wirksamsten Therapie beitragen kann. Im Gegensatz zu rein genetischen Analysen analysiert die Pharmakoskopie die tatsächliche Wirkung zahlreicher Medikamente direkt an den Krebszellen der Patientinnen und Patienten – und erlaubt so eine Aussage zur zielgerichteten Behandlung.
Ein besonderes Merkmal der RAPID-Studie: Sie ist bereits in der klinischen Anwendung. Patientinnen und Patienten können somit direkt von dieser innovativen Technologie profitieren – ein entscheidender Schritt in Richtung personalisierte Medizin im klinischen Alltag.
Zentrum für Hämatologische Neoplasien
Das Zentrum für Hämatologische Neoplasien ist eins von 17 Organzentren des Comprehensive Cancer Center Zürich (CCCZ), in denen sich zahlreiche Kliniken und Fachbereiche zusammenschliessen und interdisziplinär arbeiten. So wird das Wissen von allen Experten und Expertinnen für die verschiedenen soliden und hämatologischen Krebserkrankungen gebündelt. Dies ermöglicht eine ganzheitliche medizinische Betreuung aus einer Hand, die auf die individuellen Bedürfnisse von an Krebs erkrankten Menschen zugeschnitten ist.
Einladung zum CCCZ Oncology Symposium: Multiple Myeloma & Lymphoma
Einladung für zuweisende Kolleginnen/Kollegen und Fachpersonen.
Themen:
- Aktuelle Fortschritte in Diagnostik und Therapie
- Einblicke in laufende Studien- und Forschungsprojekte
- Möglichkeiten der interdisziplinären Zusammenarbeit und Koordination der Patientenbetreuung
Ort: Universitätsspital Zürich, Grosser Hörsaal OSTDatum: 22. September 2025, 16:00-18:15h
Wir freuen uns auf Ihre Teilnahme und den persönlichen Austausch.


